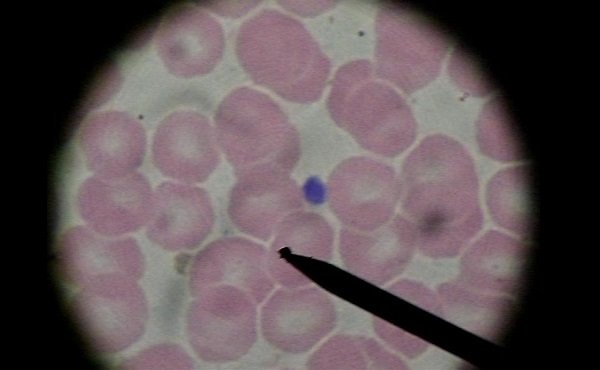

Sometida a tratamiento médico adecuado, a base de dosis intensas de cortisona, se logró remontarla de 80.000 a 90.000 pero, al reducir la dosis de medicación, bajó nuevamente a las 20.000, sin lograr remontarlas, hecho que se fue repitiendo a lo largo de varias semanas.
Al ver que no se presentaba ninguna mejoría, fue cuando decidí pedir a la sierva de Dios Montsita Grases que intercediera por ella. Al cabo de pocos días se le declaró a la niña una gripe y cuando, al efectuar un nuevo análisis, temíamos todos que nos hallaríamos ante un empeoramiento, tuvimos la gran alegría de ver que el número de plaquetas había remontado a 150.000.
La mejoría ha persistido y actualmente nuestra hijita hace una vida completamente normal.
M.B. de P.